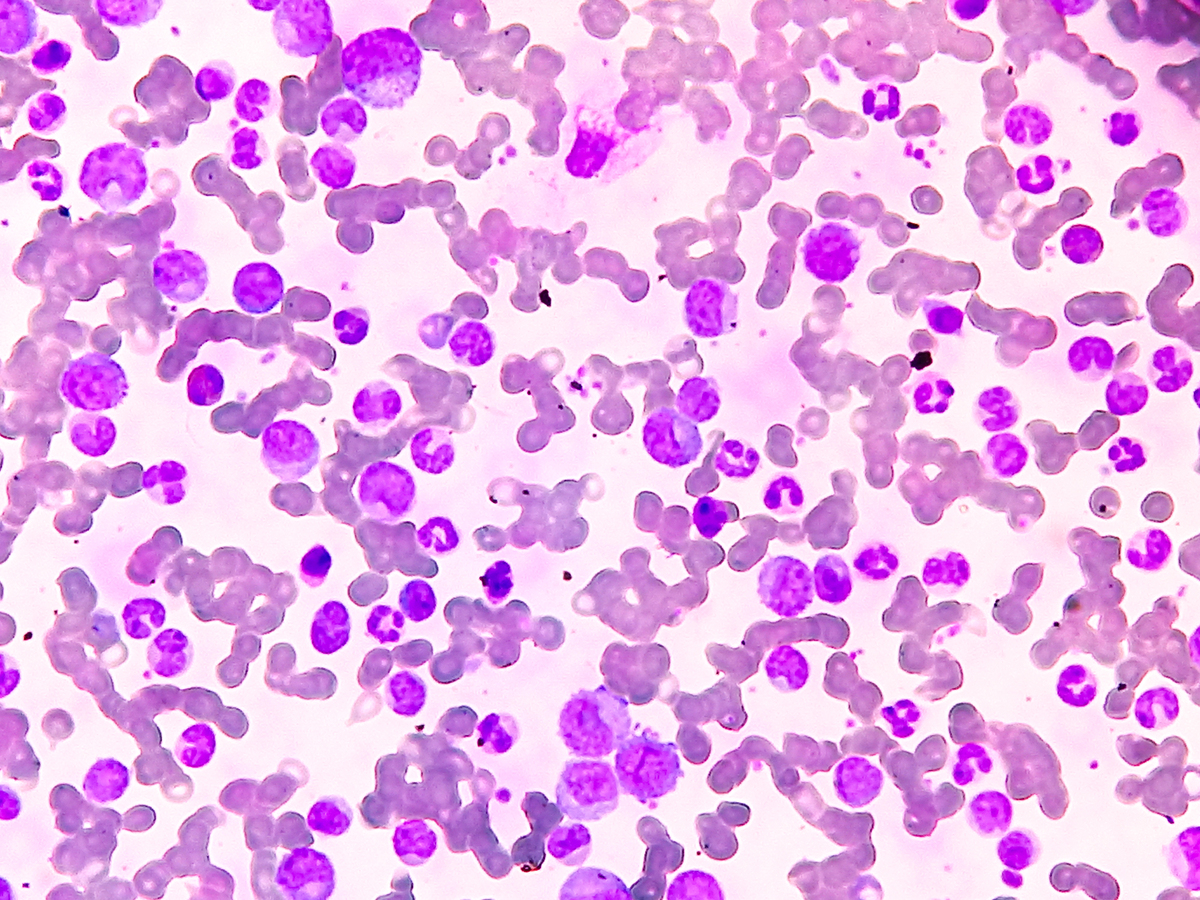
急性淋巴细胞白血病不治疗会怎样？后果很严重！

急性淋巴细胞白血病不治疗会怎样?后果很严重!
急性淋巴细胞白血病不治疗会怎样?后果很严重!
急性淋巴细胞白血病(Acute Lymphoblastic Leukemia,简称ALL)是一种进展迅速的血液癌症。如果不进行治疗,ALL可能会导致以下严重后果:
-
病情进展加重: 没有治疗的情况下,ALL会不断进展,白血病细胞会不受控制地增殖,占据正常造血组织的空间,导致造血功能受到抑制。
-
免疫系统受损: ALL会破坏正常的免疫系统,使患者更容易感染细菌、病毒和真菌等病原体。由于白血病细胞替代了正常的免疫细胞,患者的身体难以对抗感染。
-
贫血和出血: ALL破坏了骨髓中正常造血细胞的产生,导致贫血和血小板减少,患者可能出现疲劳、气促、易出血等症状。
-
骨骼病变: ALL可累及骨髓,在骨骼中形成白血病细胞的病灶,导致骨骼痛和骨折的风险增加。
总之,不进行治疗的ALL患者病情会不断恶化,生存期将显著缩短。因此,早期诊断和及时治疗是关键。 如果怀疑患有ALL,请尽早咨询专业医生以获取确诊和制定适当治疗计划的建议。
原文地址: https://www.cveoy.top/t/topic/cjK7 著作权归作者所有。请勿转载和采集!